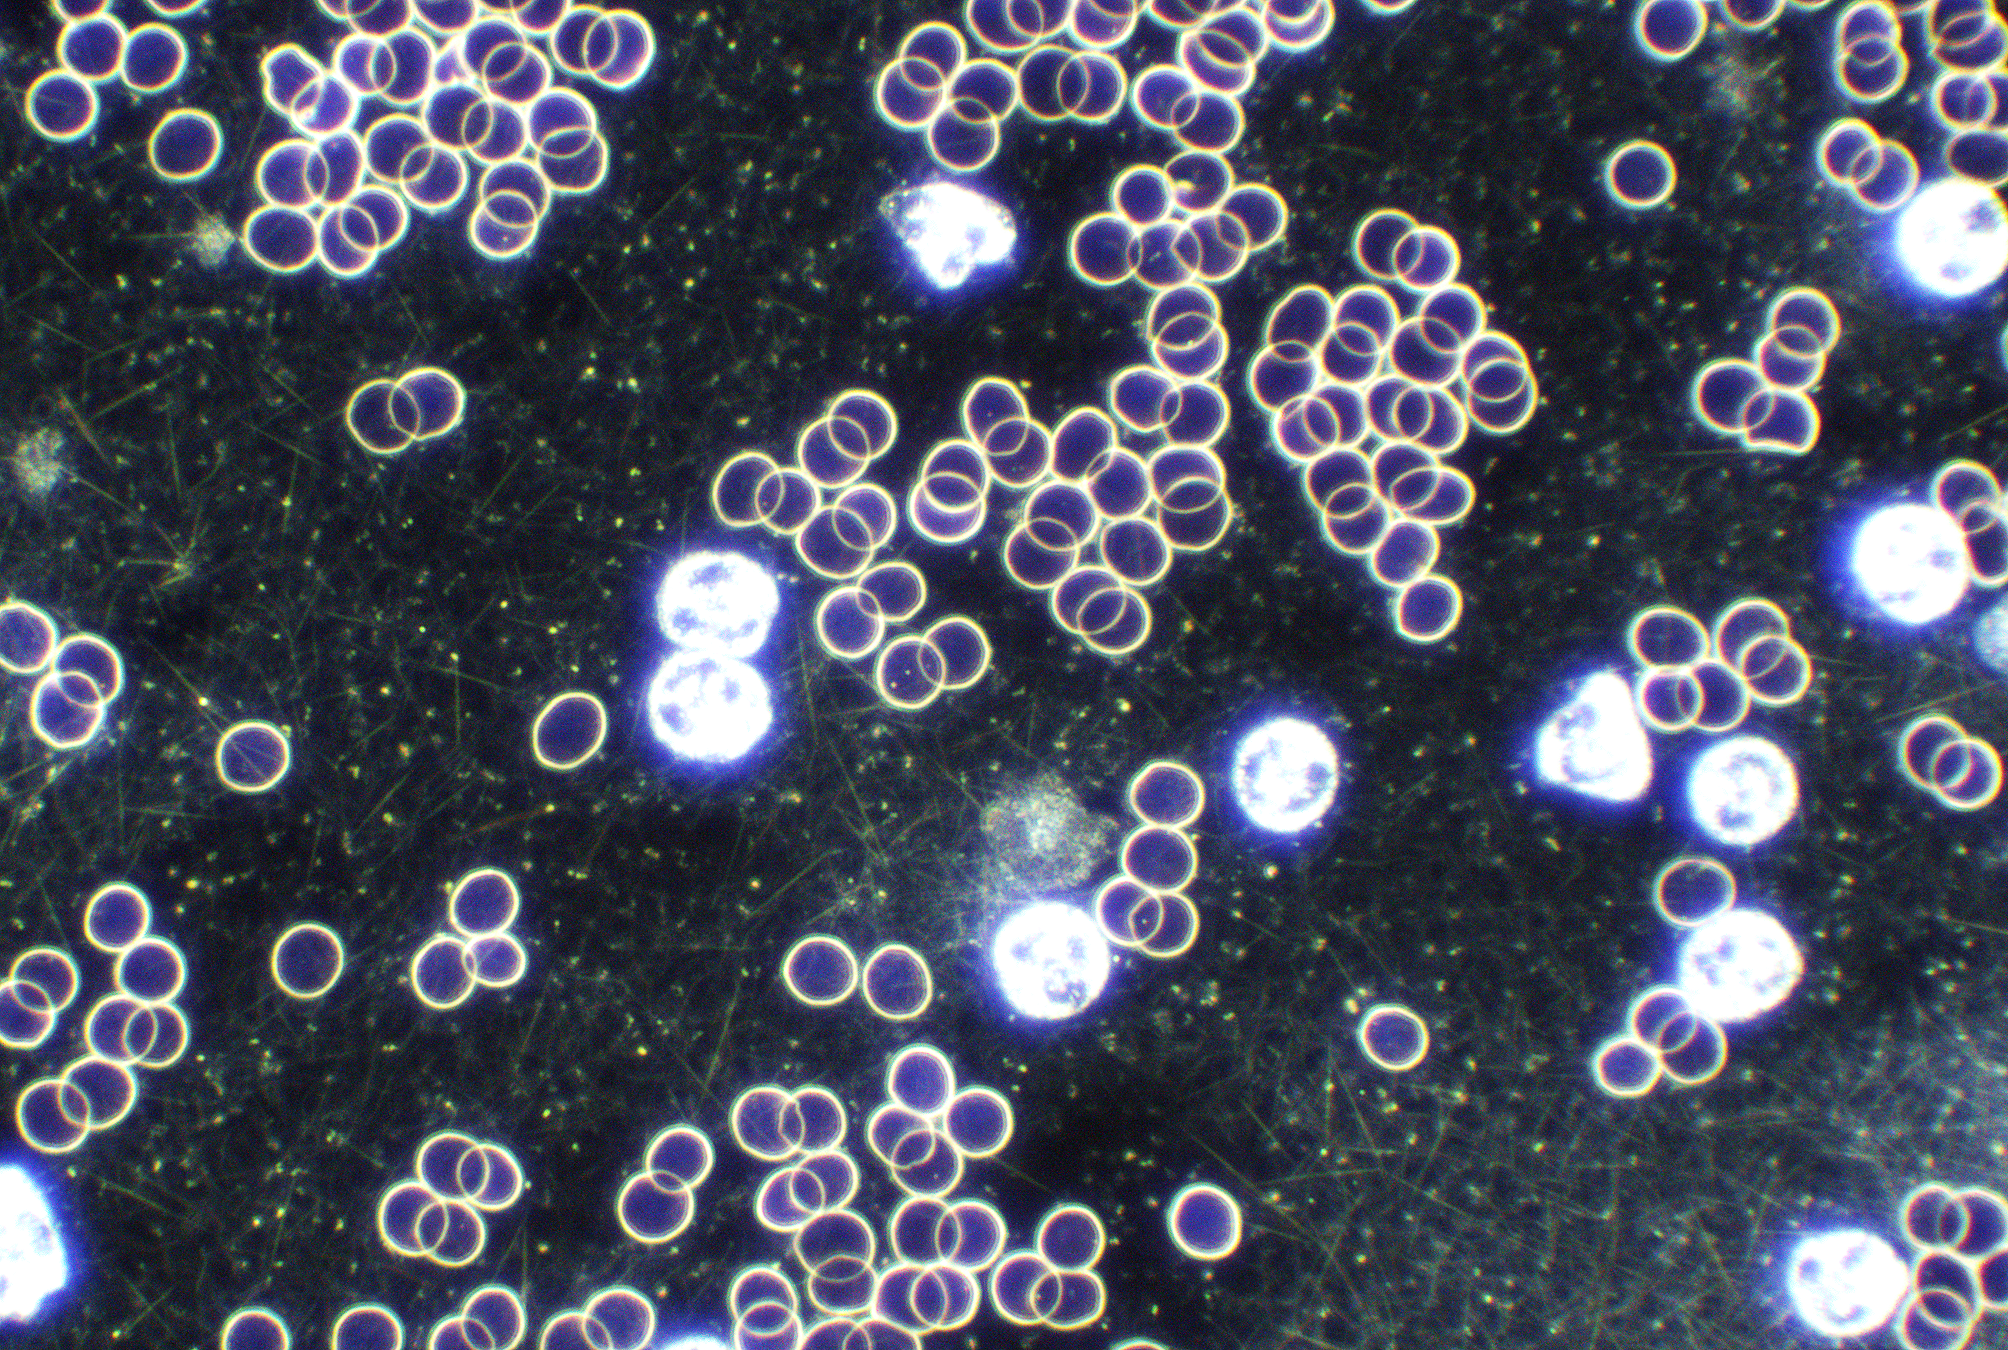
Same%2Bman%2Bw%253A%2Bprostate%2BC.png

Live Blood
Microscopy
Where your bodies story
Becomes visible

The River of Life
Flowing
Within You
In nearly every spiritual tradition, blood is understood as something sacred — the carrier
of life force
The Importance of
Clean Blood
We live in a world that is, by design, deeply toxic. Our food supply has been stripped, our water has been altered, our air carries contaminants, and our daily environment is saturated with electromagnetic frequencies, synthetic chemicals, and an endless stream of mental and emotional stress. Our bodies have done their best to adapt — but adaptation to toxicity is not the same as health. It is survival.
Clean, oxygenated, well-nourished blood is the foundation upon which every system of the body depends. The brain cannot think clearly when the blood that feeds it is thick, acidic, and starved of nutrients. The heart cannot sustain real joy and vitality when it is pumping blood burdened with inflammation and bacteria. True healing — not management, but healing — begins at the cellular level. When your blood is clean, your cells can communicate properly, your organs can do their work, your immune system can respond with intelligence, and your body can begin the deep, quiet process of restoring itself to wholeness.

At Human’s Recovery, we offer Live & Dry blood Cell Analysis
to give you a real-time, honest picture of your health from the inside out.

Live Blood Cell Analysis
A single drop of blood is taken from the fingertip and placed directly onto a microscope slide while it is still alive and moving. Viewed under a high-powered dark-field microscope, we can observe your red blood cells, white blood cells, platelets, and plasma in their natural, living state — right before your eyes. The shape, size, movement, and behavior of your cells reveal an extraordinary amount of information: How sticky or thick your blood is, how much bacteria and parasites are in the plasma, nutritional deficiencies, how your body is eliminating waste, immune activity, hydration levels, and much more. This part of the reading tells us the current health of your blood based off of how your heal is in the exact moment of taking the sample.

Dry Blood Cell Analysis
Also known as Oxidative Stress Analysis. This method examines a series of dried blood droplets that are layered and allowed to coagulate on a slide. Once dried, the pattern of clotting — the way the blood settles, where it fractures, where it is dense or absent — speaks to chronic patterns within the body. While live blood shows what is happening right now, dry blood reveals what has been accumulating over time: Hormonal imbalances, parasites in the tissues, heavy metal presence, systemic inflammation, gut issues, organ stress, the residue of long-held toxicity, and more.
Together, they form a complete story.




What to Expect
When You Come In
01
The Intake Conversation
Diet is and lifestyle isn everything. This initial conversation is to get an idea of what you put into your body on a daily/weekly/monthly basis, and what types of self care routines you already have implemented in your regular routine. We will also go over what to expect from the session.
02
The Blood Sample
A small, single drop of blood is taken from the fingertip using a sterile lancet, and is placed on a clean slide to asses the Live Blood Analysis. A second, larger drop is then taken and placed onto a separate clean slide in 6 layers where it dries to create the oxidative stress pattern for the Dry Blood Analysis. The process is quick, simple, and nearly painless. No laboratory, no waiting, no vials.
03
Viewing the Live Blood Sample
Your blood is immediately place under the microscope and projected onto a screen so you can witness it in real time alongside us. This moment alone is often profoundly awakening. For many people, seeing their own living blood cells for the first time is a visceral reminder that the body is not a machine — it is a living, breathing, intelligent universe.
04
Dry Blood Analysis
Once the Live Blood is completed, the dry blood will be ready for analysis. We examine the formations of together and discuss what long-term patterns and deeper systemic information are present.
05
The Reading & Guidance
We walk you through everything we observe — clearly, honestly, and without fear. You will receive a full explanation of what is showing up in your blood, what it means for your wellbeing, and what you can begin doing to support your body's return to balance. Guidance is rooted in natural, whole-body healing: nutrition, hydration, detoxification, nervous system care, a clean environment, and lifestyle.
06
Your Personalized Path Forward
You leave not with a diagnosis, but with a map — a clear, actionable sense of where your body is and what it needs. Many clients combine their blood analysis with 1:1 life coaching, home detox sessions, and/or neurofeedback to build a complete, integrated approach to their healing journey.
Our Philosophy and Protocol
Our philosophy is based on the knowing that god created man perfectly from the very beginning, and that our bodies are naturally able to heal themselves when we align as closely as possible to gods original creation. The health protocol provided at Human’s Recovery is not just a quick fix detox plan, but a program put together for those who are willing to gently nourish their bodies, and radically change their lifestyle to regain optimal health. We will guide you on the path towards deep physical healing, but the true depth of your healing is all based on your willingness to commit to your health, unlearn some of the collective health programming, and take the action you take towards wellness on your new path moving forward.
An Exciting Partnership
Human’s Recovery is teaming up with a local natural health practitioner to give you an even deeper understanding of the current state of your health. Together we offer a full picture overview of your body’s health with:
Iridology • Body Scan • & Live Blood.
Reach out directly for more information!

REACH OUT TODAY.
CARMEN DOLLARD
humansrecovery@gmail.com
BASED OUT OF LANTZVILLE & NANOOSE BAY
I look forward to connecting with you!
